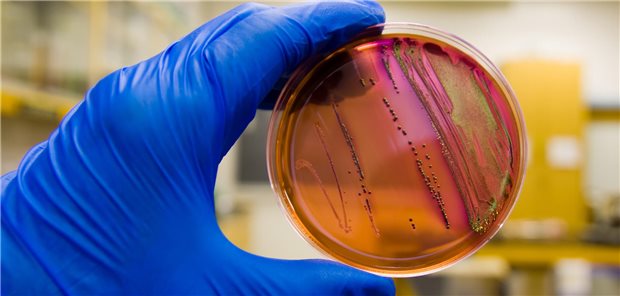
MRSA-Nachweis im Labor

21.07.2025
|
Antworten auf gängige Fragen
Doxy-PEP zur Prävention von sexuell übertragbaren Infektionen: Wer, was, wann?
16.07.2025
|
Empfehlungen der WHO
Bei Ko-Infektion mit HIV und Mpox antivirale Therapie schnellstmöglich beginnen!
24.07.2024
|